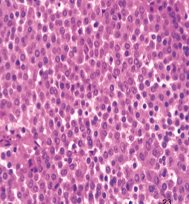
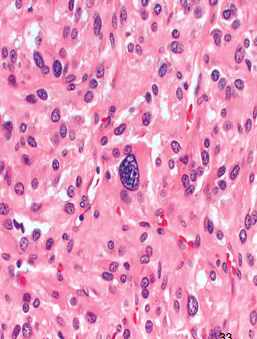

anterior pituitary:
- routine hematoxylin and eosin stained sections show a colorful array of cells
- varied cells - stains for releasing hormones w/ini cells of pituitary (5 diff’t types of cells)
- pituitary adenoma


Craniopharyngioma
Adamantinomatous: children, squamous epithelium, wet keratin and calcification, cysts contain “machine oil”

Craniopharyngioma
Papillary: found in adults; lack keratin, calcification and cysts

parathyroid gland H&E stain:
- chief cells
- oxyphil cells
- parathyroid hormone receptors

PRIMARY HYPERPARATHYROIDISM:
- well-circumscribed, tan, brown nodule
- rim of compressed, non-neoplastic parathyroid tissue separated by fibrous capsule present
- composed of nearly all chief cells & few oxyphil cells

more on primary hyperparathyroidism, showing hyperplasia (sporadic/component of MEN syndrome)

skeletal changes seen in PRIMARY HYPERPARATHYROIDISM;
- Resultant bone comprised of widely-spaced thin trabeculae and in severe cases marrow with hemorrhage, cyst formation and fibrosis (osteitis fibrosa cystica)
- Can form masses (brown tumors) composed of giant cells and hemorrhagic debris.

Thyroid
- C cells (parafollicular cells)
- Secrete the hormone Calcitonin
- Lowers serum calcium by promoting bone absorption of calcium and inhibiting bone resorption by osteoclasts
- Goitrogens
what disease?

Graves disease
- symmetrical diffuse hyperplasia of thyroid gland; soft, meaty cut surface
- in UNTREATED cases, can see tall follicular epithelial cells; forming papillae that encroach on colloid; pale colloid w/ scalloped margins
which disease?

HASIMOTO THYROIDITIS
- diffusely enlarged with intact capsule
- pale yellow-tan, firm, nodular cut surface
- mononuclear inflammatory infiltrate with well formed germinal centers, atrophic follicles, Hürthle cell change and fibrosis
what pathology?

MULTINODULAR GOITER - on the RIGHT
- colloid-rich follicles intermixed w/ areas of follicular hyperplasia (no distinct capsule)
- Cut surface shows irregular nodules w/ hemorrhage, fibrosis, cystic change, and calcification
what pathology?

FOLLICULAR ADENOMA
- Encapsulated lesion, averages 3 cm;
- composed of uniform-appearing follicles containing colloid
what carcinoma?
papillary carcinoma of thyroid gland

what type of carcinoma?
FOLLICULAR CARCINOMA of thyroid gland

what type of carcinoma?
medullary carcinoma of thyroid gland

type of tissue?

Adrenal gland:
- cortex has 3 layers
- medulla: is composed of chromaffin cells
what pathology?

diffuse adrenocortical hyperplasia
what pathology?

adrenocortical adenoma:
- solitary
- well-circumscribed
- yellow
what pathology?

adrenocortical CARCINOMA
what pathology

primary hypoadrenalism
what pathology?
pheochromocytoma:
–Small circumscribed lesions confined to adrenal to large hemorrhagic masses
–Composed of polygonal to spindle cells clustered with sustentacular cells into small nests or alveoli (zellballen) by a rich vascular network.
what pathology

Insulinoma (type of pancreatic endocrine neoplasm)
- Most are solitary, usually small, encapsulated, pale to red-brown nodules located anywhere in the pancreas
- histologically bland and look remarkably like giant islets; presence of extracellular amyloid


